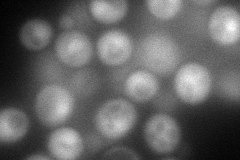
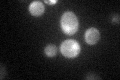

View description
Basic leucine zipper (bZIP) transcriptional activator of amino acid biosynthetic genes in response to amino acid starvation; expression is tightly regulated at both the transcriptional and translational levels
Localization:
Intensity:
Fold change:
Significance:
-
C’ GFP library in SD

nucleus21.93 -
N' NOP1pr-GFP in SD
cytosol,nucleus112.751 -
N' TEF2pr-mCherry in SD

cytosolN/A -
N' NATIVEpr-GFP in SD

nucleus28.3017 -
N' TEF2pr-VC and Cyto-VN in SD

cytosol32.0217 -
C’ GFP library in SD+DTT

nucleus18.790.85No -
C’ GFP library in SD+H2O2

nucleus33.281.51Yes -
C’ GFP library in Starvation Media
nucleus18.020.82Yes -
C’ GFP library on the background of Pup2-DaMP

nucleus -
C’ GFP library on the background of CCT mutant

nucleus23.45171.06904No
